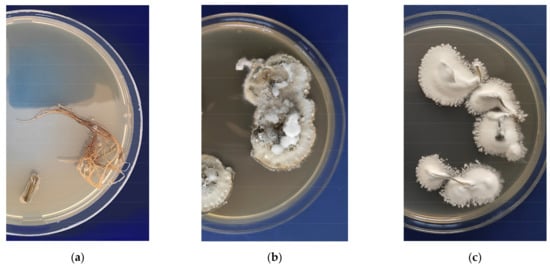

Abstract
Endophytic entomopathogenic fungi are promising agents for the promotion of plant growth, the activation of immunity, and protection against phytopathogens. However, physiological changes in plants after treatment with fungi are insufficiently studied. We investigated the effect of potato inoculation with conidia from Metarhizium robertsii and Beauveria bassiana on the growth (fresh and dry weight, length of shoots and roots, counts of stolons and leaves, and total surface area of leaves) and physiological parameters (pigment contents, free proline and malondialdehyde content, and activity of antioxidant enzymes) at the initial stage of the plant–fungus interaction (seven days) under hydroponic conditions. The results showed that the fungi could act as an immune-modulating factor for plants based on the increase in malondialdehyde and proline contents. At the same time, we observed growth retardation and a decrease in the content of photosynthetic pigments, which may be caused by a tradeoff between plant growth and the immune response.
1. Introduction
Endophytic fungi are attracting researchers’ interest because the plants associated with them show increased plant productivity, as well as resistance to biotic and abiotic stresses. Endophytism was identified for insect-pathogenic fungi more than 30 years ago [1,2]. The experimental confirmation of the capacity of insect-pathogenic fungi to colonize plants, including agricultural crops, is widely presented in different studies [3,4,5,6,7,8]. Most investigations have concentrated on the study of the endophytic competence of ascomycetes from the genera Metarhizium and Beauveria due to their widespread distribution and active use for the environmentally friendly control of herbivorous and blood-sucking insects [9,10]. Endophytic insect-pathogenic fungi (EIPF) are regarded as facultative endophytes or as fungi with multifunctional lifestyles combining entomopathogenic properties with the ability to exist in the rhizosphere and internal plant tissues [4]. However, EIPF also exhibits many of the beneficial properties of obligate endophytes.
Most investigations are focused on the ability of EIPF to promote plant growth and its capacity to minimize the damage caused by pests and pathogens. The growth-stimulating effect of EIPF has been studied in detail. This effect has been associated with the transmission of nitrogen via mycelia to plant roots [11,12], the induction of proteins involved in photosynthesis and energy metabolism in plants [13], the activation of phytohormone production in colonized plants [14], and the synthesis of hormone-like substances by fungi [15]. The protective effect of the endophytic fungi Beauveria and Metarhizium against the fungal phytopathogens Pythium myriotylum, Rhizoctonia solani, Fusarium oxysporum, Botrytis cinerea, Sclerotinia sclerotiorum, and others has been shown in a number of studies [14,16,17,18,19,20]. However, the mechanism of phytopathogenic microorganism suppression by EIPF has not been thoroughly studied. It is assumed that the potential mechanisms of plant pathogen inhibition by endophytes include several mechanisms: direct effects (antagonistic interaction between endophytes and pathogens), indirect effects (enhancement plant defense), and ecological effects (occupation of ecological niche) [21]. Currently, there is enough evidence for the antagonistic activity of EIPF against fungal plant pathogens during cocultivation [20,22,23,24]. Investigations on the induction of protective reactions in response to EIPF colonization are rare and sketchy. For example, it has been shown that entomopathogenic fungi increase the activity of plant protective compounds [25,26,27]. An assessment of transcriptomic responses of Arabidopsis thaliana to B. bassiana colonization [14] as well as Zea mays to M. robertsii colonization [28] revealed changes in the expression of genes related to jasmonic (JA) and salicylic acid (SA) signaling pathways. In our previous studies, we showed that M. robertsii and B. bassiana had direct and indirect inhibitory effects toward the phytopathogen Rhizoctonia solani caused by changes in peroxidase activity in potato plants during colonization by EIPF [29]. We speculate that the characteristics of the interactions at early and subsequent stages of the plant–fungus relationship will be different. Apparently, the plant may respond to primary contact with EIPF via “mild” stress (such as elicitors), which subsequently leads to protective effects.
It is known that endophytes activate multiple defense responses directed at the formation of chemical and mechanical barriers against pathogens. A cascade of defense reactions leads to the formation of inducted systemic resistance (ISR) and systemic acquired resistance (SAR) [21,30,31]. It is apparent that defense mechanisms are multilayered; they replicate each other and become more complicated during coevolution [30,32]. Plants generally respond to elicitors by generating reactive oxygen species (ROS), including the free radicals H2O2 (hydrogen peroxide), O2¯ (superoxide), and OH¯ (hydroxyl radicals). Protective enzymes, including superoxide dismutase, catalase, and ascorbate peroxidase, actively participate in the neutralization of the toxic effects of ROS [33]. The high activity of those enzymes is an important component of plant resistance [34,35].
Notably, the polyfunctional amino acid proline is one of the most important nonenzymatic antioxidants. An increase in the free proline level is a physiological reaction of many plants in response to various stresses [36]. Proline is capable of protecting cells against damage by acting as an osmotic agent and free radical scavenger. Proline accumulates under stress conditions, and as it breaks down, it provides an energy reserve for further stimulating plant growth [37].
Because the induced production of ROS and their neutralization are energetically costly, the question about the “price” of resistance often arises [38]. In the process of selection of endophyte-plant pairs, it is important to assess not only the increase in resistance to pathogenic organisms but also to minimize the possible negative effect of endophytic colonization. It should be noted that potatoes may be only occasionally colonized by EIPF in agrosystems with natural loads of Metarhizium and Beauveria in soils [39]. The fungal community of potato’s internal tissues is represented mainly by phytopathogens such as Cladosporium, Fusarium, and Alternaria [39]. Therefore, the coadaptive potato–EIPF system is not stable in agrosystems. However, treatment of potatoes with high concentrations of EIPF in the laboratory and under field conditions leads to successful endophytic colonization [29,40,41]. Since Metarhizium and Beauveria are not stable colonizers of potatoes, we expected to observe a pronounced potato physiological response at the early stage of colonization.
In this paper, we evaluated alterations in growth parameters, photosynthetic pigment contents, and defense reactions in virus-free hydroponically grown regenerant potato plants during the early stage of the interaction between plants and the fungi M. robertsii and B. bassiana. The hydroponic conditions of the experiment allowed us to estimate the effect of fungi on plants in a balanced nutrient medium and minimize the influence of environmental factors. Hydroponic systems have successfully proven themselves in the study of the influence of endophytes on plants [42,43]. An analysis of the early plant response to EIPF colonization can help us understand plant resistance mechanism formation and reveal the potential of EIPF as a multifunctional biocontrol agent.
2. Materials and Methods
2.1. Fungal Isolates and Their Cultivation
Isolates of the entomopathogenic fungi Metarhizium robertsii (strain P-72) and Beauveria bassiana (strain Sar-31) from the collection of microorganisms at the Institute of Systematics and Ecology of Animals (Siberian Branch of the Russian Academy of Science) were used. The species were previously identified using the translation elongation factor (EF1α) sequence [44] and compared to the sequence of the GenBank. The sequences are available in GenBank under accession numbers KP172147.2 (P-72) and MZ564259 (Sar-31).
Cultures were grown on Sabouraud dextrose agar with 0.25% yeast extract (SDAY) at 26 °C in the dark for 10 days. The conidial mass was harvested and suspended in water–Tween-80 solution (0.03%). The concentration of conidia was determined using a Neubauer hemocytometer (Fristaden Lab, USA). Suspensions of conidia were added to the liquid medium in which plants were grown, and the final concentration in the medium was 1 × 106 conidia/mL. The effective concentration of conidia was selected from preliminary assays.
2.2. Plant Cultivation and Treatment
Hydroponic culture of plants of the potato (Solanum tuberosum L.) cv. Lugovskoi (identifier 8,301,891) propagated in vitro were used in the experiments. The potato plantlets were regenerated from aseptic stem-node potato meristems and cultured on Murashige and Skoog agar medium (MS) [45] for 30 days (Figure A1a (Appendix A)). Then, the seedlings were adapted to liquid half-strength modified Murashige and Skoog agar medium (0.5MS without sucrose and agar) for two weeks. Seedlings were cultivated in a controlled climate chamber using L36 W/77 Fluora luminescent lamps (Osram, Germany; 100 μM photons m−2 s−1) with a 16-h day/night photoperiod and day/night temperatures of 23 ± 0.5 °C/20 ± 0.5 °C. After adaptation, seedlings were cultivated in liquid medium (0.5MS, without sucrose and agar) and then transferred to the same medium freshly inoculated with fungal conidia or to conidia-free medium (untreated plants-control) (Figure A1b). Seven days after fungal treatment, plant materials were collected for analysis. This is the optimal period to get an adequate early response in plants (growth and physiological parameters). A longer incubation period may lead to contamination of the nutrient medium with foreign microorganisms.
2.3. Plant Colonization Essay
The frequency of plant colonization with entomopathogenic fungi was estimated by plating plant tissues on media. Plant roots were sterilized by 0.5% hypochlorite for 2 min, 70% ethanol for 2 min, and rinsed in sterile autoclaved water [46]. Then, plant tissues were imprinted [47] and plated on modified Sabouraud agar (10 g peptone, 40 g D-glucose anhydrous, 20 g agar, 1 g yeast extract) supplemented by 0.35 g/L cetyl trimethyl ammonium bromide; 0.05 g/L cycloheximide; 0.05 g/L tetracycline; and 0.6 g/L streptomycin (for inhibition of saprotrophic fungi and bacteria) in 90 mm Petri dishes (one plant per dish). The dishes were incubated for 10 days at 24 °C. After incubation, the number of plants overgrown by Metarhizium and Beauveria was counted. Samples showing fungal growth on the imprints were excluded from the analysis. Representative colonies were reisolated on Sabouraud agar for molecular analysis to confirm the isolates as belonging to the studied fungi. DNA extraction, amplification, sequencing of the TEF region, and blast analysis were performed as described in previous work [44]. Root microscopy was performed using a light microscope (Axioskop 40, Carl Zeiss, Germany; magnification 200×) after vortexing the roots in water–Tween-80 solution (0.03%).
2.4. Plant Growth Parameters and Leaf Photosynthetic Pigment Contents
The lengths of potato plant roots and shoots were estimated and expressed in centimeters. The total leaf surface area for each plant was calculated from the paper leaf template and expressed in square centimeters. The weight of the fresh root and shoot plant biomass (FW) were determined after drying by filter paper at once. To obtain dry root and shoot material (DW), the organs were frozen at −80 °C and lyophilized to constant weight. All measurements were performed with an accuracy of 1 mg.
The photosynthetic pigment contents were determined in fresh leaves from the middle nodes of the plants. Leaf samples (15 mg) were fixed in 96% ethanol (200 μL), homogenized using clean Eppendorf tubes and plastic pistils, and centrifuged using a MiniSpin centrifuge (Eppendorf, Germany) at 8000 rpm for 10 min. The supernatants were transferred to clean Eppendorf tubes and brought to 1.5 mL with 96% ethanol. The optical density (D) of the solutions was measured immediately at wavelengths of 470, 664, 648, and 720 nm on a spectrophotometer (Genesys 10S UV-Vis, Thermo Scientific, USA). Samples containing free 96% ethanol were used as a control. The pigment concentration (C) was calculated according to Lichtenthaler [48] using the following formulas:
where C is the concentration, V is the volume of the extract, and n is the sample weight (g), chl, chlorophyll, and carot, carotenoids.
C chl a = 13.36 × D664.2 − 5.19 × D648.6
C chl b = 27.43 × D648.6 − 8.12 × D664.2
C chl a + b = 5.24 × D664.2 + 22.24 × D648.6
C carot = (1000 × D470 × 2.13 × C chl a − 97.64 × C chl b)/209
To estimate the amount of pigments per sample weight (A):
A = C × V/1000 × n,
2.5. Lipid Peroxidation
Lipid peroxidation (LPO) was determined by the main reaction product malondialdehyde (MDA) using the method of Heath and Parker [49]. One hundred milligrams of the plant material (roots, stems, and leaves) was homogenized in 1 mL of 20% (w/v) trichloroacetic acid (TCA). The homogenate was centrifuged using a 5430R centrifuge (Eppendorf, Germany) for 15 min at 10,000× g and 4 °C. To 500 μL of supernatant, 1.5 mL of 0.5% thiobarbituric acid (TBA) was added, mixed, and incubated for 30 min at 95 °C. After incubation, samples were transferred to an ice bath for cooling and centrifuged for 12 min at 10,000× g. Absorption was measured using a spectrophotometer (Genesys 10S UV-Vis Thermo Electron, Germany) at wavelengths of 532 and 600 nm. Due to the reactivity of TBA with several reactive substances in biological samples, thiobarbituric acid reactive substances (TBARS) are now commonly used instead of MDA.
The TBARS content was calculated using the formula:
where C is the TBARS concentration of μg/g FW; E is the optical density of the solution at wavelengths of 532 and 600 nm; V1 is the volume of TBA, mL; V2 is the supernatant volume, mL; and m is the sample weight, g.
C = (E532 − E600) × V1 × 2/156 × V2 × m
2.6. Activity of Antioxidant Enzymes in the Leaves
The activities of total superoxide dismutase (SOD) and peroxidase (POX) were measured in crude extracts of leaf tissues. Leaf samples (200 mg) were ground in liquid nitrogen using clean Eppendorf tubes and plastic pistils. The homogenate was mixed with 0.066 M K/Na-phosphate buffer, pH 7.4, containing 1 mM of dithiothreitol (DTT) and 0.5 mM of phenylmethylsulfonyl fluoride (PMSF) in dimethyl sulfoxide (DMSO) with insoluble polyvinylpyrrolidone (PVP). After centrifugation of the homogenate at 10,000× g for 20 min at 4 °C using a 5430R centrifuge (Eppendorf, Germany), the resulting supernatant was used to measure enzyme activity. To determine total SOD activity, a method adapted from Beauchamp and Fridovich [50] was used. We added 40 μL of supernatant to 2 mL of the reaction medium containing 1.75 mL of 50 mM Tris–HCl buffer (pH 7.8), 0.2 mL of 0.1 M DL-methionine, 0.063 mL of 1.7 mM nitro blue tetrazolium (Sigma-Aldrich, Saint Louis, Missouri, USA), 0.047 mL of 1% Triton X-100, and 0.060 mL of 0.004% riboflavin. The reaction proceeded under a model F36 W/54 luminescent lamp (Philips, Hungary) for 30 min. Absorption was measured using a spectrophotometer (Genesys 10S UV-Vis Thermo Electron) at a wavelength of 560 nm. SOD activity was calculated in units of transmission density (ΔA) of the incubation mixture during the reaction for 1 min and 1 mg of protein.
The activity of peroxidase was measured according to Shevyakova et al. [51] with H2O2 and guaiacol (Fluka, Switzerland), which were used as a substrate and hydrogen donor, respectively. To 50 μL of supernatant, added 1.95 mL of 0.066 M potassium phosphate buffer (pH 7.4) containing 200 μL of 7 mM guaiacol and 250 μL of 0.01 M H2O2. Absorption was measured using a spectrophotometer (Genesys 10S UV-Vis Thermo Electron) at a wavelength of 470 nm. POX activity was expressed as mM guaiacol/(mg protein min).
The protein content in the samples was determined according to Esen [52]. For the calibration curve, bovine serum albumin was used.
2.7. Free Proline Content in Plants
The free proline concentration was calculated according to Bates et al. [53] in roots, stems, and leaves. Forty milligrams of plant material was ground as described above. Distilled water (1 mL) was added to each tube with disrupted material and incubated for 30 min at 98 °C. The extract (200 μL) was transferred to volumetric tubes, and 800 μL of distilled water, 1 mL of glacial acetic acid, and 1 mL of ninhydrin reagent (1.25 g of ninhydrin, 20 mL of 6 M H3PO4, 30 mL of glacial acetic acid) were added; samples were then incubated for 1 h in a boiling water bath. Distilled water was added to the control samples. The optical density was measured using a spectrophotometer (Genesys 10S UV-Vis Thermo Electron) at a wavelength of 520 nm. The proline content was calculated using the formula:
where C is the concentration of proline, μM/g FW; E is the optical density; k is the coefficient calculated from the calibration curve; V is the final volume of extract, mL; and m is the weight of the sample, g.
C = E × k × (V/m × 1000)
2.8. Statistical Analyses
The assessment of fresh weight, organ length, and morphometric parameters was carried out on 50 plants; the organ’s dry weight, colonization of plants, contents of pigments, proline, and TBARS was carried out on 25–30 plants; and for the assessment of enzyme activity, 15–20 plants were used for each treatment. The experiments were conducted twice. Data were analyzed using the program Statistica 8.0 (StatSoft Inc, Tulsa, OK, USA) and PAST 3 [54]. The normality of the data distribution was confirmed with the Shapiro–Wilk W test. Normally distributed data were analyzed by one-way ANOVA followed by Tukey’s post hoc test. Non-normally distributed data were analyzed with the Kruskal–Wallis test followed by Dunn’s post hoc test. The chi-square test was used to estimate differences in the fungal colonization of plants. Data are presented as the mean values and standard errors (SEs).
3. Results
3.1. Root Colonization with Fungi
Root colonization of potatoes was registered at 7 days after planting in medium inoculated with conidia. Both fungi B. bassiana and M. robertsii were detected in the roots (Figure 1). The percentage of plants colonized with entomopathogenic fungi was 68% and 80% after M. robertsii and B. bassiana treatments, respectively, and the difference between these treatments was not significant (χ2 = 0.62, p = 0.43). Microscopic analysis of roots confirmed the colonization of roots with both fungi. Mycelia were observed mainly in the growth zone of root hairs, and mycelial penetration into the tissues of the roots took place in the intercellular area (Figure A2). The growth of fungi was not registered in the control plant in either the plating on medium or microscopy assays. It is important to note that the proportion of germinated conidia was only 3–5% in the bulk MS medium with cultivated plants after 7 days of the experiment.
Figure 1.
Fungal reisolation from the surface of sterilized roots on Sabouraud modified medium: (a) Control; (b) M. robertsii (strain P-72); (c) B. bassiana (strain Sar-31).
Analysis of the TEF region of reisolated cultures confirmed their belonging to the investigated fungi. The identity of M. robertsii and B. bassiana reisolated strains was 100% with the strains P-72 (KP172147.2) and Sar-31 (MZ564259), respectively.
3.2. Effect of the EIPF on Plant Growth
The one-week cultivation of potato plants with EIPF conidia caused a slight decrease in several growth parameters (Figure 2, Table 1). Inoculation with M. robertsii conidia led to a significant decrease in total fresh plant weight (FW) by 13.32% (Dunn’s test, p ≤ 0.038, compared to the control and B. bassiana) and to a decrease in the shoot and root lengths by 13.04 and 15.76%, respectively (p < 0.001 compared to the control and B. bassiana, Table 1). However, the decrease in total dry plant weight (DW) after treatment with M. robertsii was insignificant. Treatment of potato plants with B. bassiana did not lead to significant changes in total FW, DW, or linear dimensions relative to the control (p ≥ 0.78, Table 1).

Figure 2.
Growth response of Solanum tuberosum plants to nutrient medium (0.5 MS) with the addition of conidia from the entomopathogenic fungi M. robertsii (P-72) and B. bassiana (Sar-31) (1 × 106 spores/mL). Exposure—7 days.

Table 1.
Effect of treatment with EIPF on plant growth: length (cm) and weight (g). Values are the means ± SE. The same letters in a raw indicate insignificant differences between treatments (Dunn’s test, p > 0.05).
Regarding changes in shoot and root FW and DW, there were no significant differences between the control and treated plants. However, slight trends of a decrease in these parameters were observed after treatment with M. robertsii. For example, the fresh weight of roots decreased at the level of marginal significance (p = 0.057 compared to the control and B. bassiana). Significant differences in the shoot/root ratio for both FW and DW were not registered after treatment with either fungus compared with the control (p ≥ 0.43).
No significant effect of EIPF on stolon formation was revealed (p ≥ 0.13 compared with the control, Table 2). However, plants treated with both fungi M. robertsii and B. bassiana had significantly decreased leaf numbers (p = 0.028 and p = 0.003 relative to the control, respectively). In turn, the area of assimilating organs of the experimental plants also decreased. A significant decrease in the leaf surface area was observed under the influence of M. robertsii (p = 0.008, Table 2).

Table 2.
Effect of treatment with EIPF on the biometrics and leaf area of Solanum tuberosum (50 plants were used for each treatment). Values are means ± SE.
3.3. Effect of EIPF on the Photosynthetic Pigment Content
We showed a significant decrease in the content of photosynthetic pigments in potato plants inoculated with B. bassiana conidia (chl a—p = 0.016; carot—p = 0.004; total chl content—p = 0.029 compared to the control) but not in plants treated with M. robertsii (Table 3). Alterations in chl b content were not significant under the influence of either fungus. Treatment with B. bassiana also led to a significant decrease in the total pigment content compared to M. robertsii-treated plants (p = 0.015). Changes in the pigment compositions after B. bassiana conidia inoculation led to a significant decrease in the chl a/b ratio (p = 0.021 compared to M. robertsii-treated plants).

Table 3.
Effect of EIPF on the content of photosynthetic pigments and pigment ratio in potato leaves. Presented values are means ± SE (n = 25). The same letters in a raw indicate insignificant differences between treatments (pigment contents—Tukey HSD, p > 0.05; ratio of pigments—Dunn’s test, p > 0.05).
3.4. Effect of EIPF on Lipid Peroxidation
It was found that the early stage of the potato–EIPF interaction was accompanied by an increase in TBARS in plants (Figure 3). The maximal increase in the TBARS level was registered in potato roots (28–35%) under the influence of both M. robertsii and B. bassiana (p = 0.026 and p = 0.049 compared to the control, respectively). In the leaves, M. robertsii caused a 1.33-fold increase in the TBARS content (p ≤ 0.01 compared to control and B. bassiana), and B. bassiana had no significant effect (p = 0.70 compared to control). In the stems, treatment with fungi did not significantly change the TBARS content relative to the control; however, the general pattern of the alterations was similar to that of the TBARS level in leaves, and significant elevation was registered in M. robertsii-inoculated plants compared to B. bassiana-treated plants (p = 0.02).

Figure 3.
Effect of treatment with EIPF on the TBARS content in plant organs. Twenty-five plants were used for each treatment. The results are presented as the median, 25–75% quartile deviation and min and max values. Different letters show significant differences between treatments for each group (Dunn’s test, p < 0.05).
3.5. Effect of EIPF on the Activity of Antioxidant Enzymes
Inoculation of potato plants with M. robertsii conidia caused a significant 1.65-fold increase in POX activity in the leaves (p = 0.014 compared to the control, Table 4). However, no changes in SOD activity in the leaves were registered under the influence of this fungus (p = 0.91 in comparison with the control). Inoculation of plants with B. bassiana conidia led to a slight (1.18–1.24-fold) and insignificant increase in the activity of POX and SOD (p = 0.163 and p = 0.29 compared to the control, respectively).

Table 4.
Effect of treatment with EIPF on the activity of antioxidant enzymes in the leaves of Solanum tuberosum. Values are means ± SE (15–20 plants for each treatment).
3.6. Effect of EIPF on Proline Accumulation in Different Parts of Plants
The level of free proline accumulation in potato plant organs was estimated in response to treatment with EIPF conidia (Figure 4). We detected a significant increase in the proline content in the potato plant stems after inoculation with M. robertsii conidia compared to the control (1.9-fold; p = 0.046) and B. bassiana-treated plants (p = 0.029). Significant changes in the proline content were not registered in the roots and leaves under the influence of either EIPF (p ≥ 0.35).

Figure 4.
Effect of inoculation with EIPF on the free proline content in plant organs. Twenty-five plants were used for each treatment. The results are presented as the median, 25–75% quartile deviation and min and max values. Different letters show significant differences between treatments for each group (Dunn’s test, p < 0.05).
4. Discussion
As shown in our work, a 7-day period was enough for colonization of potato roots by both fungal species, B. bassiana and M. robertsii. The initial fungal growth on the root surface, particularly in the root hair zone, and penetration into the root tissue were registered (Figure A2). After surface sterilization, the percentage of plants with fungi-positive roots was 68–80%. Successful early colonization of Solanaceae plants is consistent with other studies carried out on sterile substrates [40,55]. In particular, colonization of potato plant leaves and stems (up to 75%) was observed 5 days after spraying with a suspension of M. brunneum strain [40]. Substrate treatment with strains of B. bassiana and M. brunneum led to sweet pepper root endophytic colonization (42–51%) after 7 days [55]. Therefore, the initial colonization of the plant organs and method of inoculation (the zone of direct contact of fungal conidia with plant tissues) are closely related.
The positive influence of EIPF on Solanaceae plant growth, such as tomatoes and potatoes, has been shown (e.g., [41,56,57,58,59]). Previously, we showed that treatment of sterile sand with tomato seedlings by M. robertsii conidia following 14 days of incubation led to elevation of plant weight [41]. In the present work, we detected a slight reduction in some parameters of the plant biomass and linear dimensions of plants on the 7th day after inoculation with M. robertsii conidia. In particular, a slight decreasing trend in root FW after treatment with M. robertsii was detected. It was shown previously that endophytic colonization may increase root biomass, including an increase in the root surface area [60]. Our opposing result may be caused by differences in the technique of plant cultivation and time points of the experiment. Additionally, we showed that treatment with both fungi caused a decrease in the leaf number and leaf area, and the effect of M. robertsii was stronger. It should be noted that the influence of EIPF on the growth parameters is most often estimated at 20–30 or more days after treatment, while we estimated the parameters in the early stages. In longer-term experiments in sterile or nonsterile substrates, growth stimulation of potatoes was recorded after treatments with Metarhizium and Beauveria species [29,41,59]. Moreover, plant growth stimulation under the influence of endophytes on nutrient-poor substrates is more pronounced [41]. The MS medium that was used in our experiments was balanced for mineral nutrition. Thus, it can be assumed that plants colonized by fungi did not have any advantages over the control plants.
Inoculation with B. bassiana caused a decrease in the amount of photosynthetic pigments. Information about the effect of endophytes on the photosynthetic pigment composition of plants is contradictory. Studies have shown an increase in the total chlorophyll content due to plant colonization by EIPF [61,62,63,64]; however, the chlorophyll content was estimated at a later time post-treatment (from 20 to 93 days). In particular, an increase in chlorophyll content was noted during the colonization of sorghum with B. bassiana and M. brunneum [61] in tomato and in wheat after seed inoculation with B. bassiana [62]. Chlorphyll was also increased in sorghum and wheat after treatment of soil with M. brunneum [63] and in cardamom after the treatment of the soil surface with Lecanicillium psalliotae [64]. The authors [62,64] explained this elevation as an increase in iron availability from the substrate due to fungal siderophores in colonized plants. Racić et al. [65] showed that tomato colonization with Trichoderma brevicompactum under normal moisture did not affect the content of tomato photosynthetic pigments, but under dry conditions, the total chlorophyll content increased significantly in comparison with noncolonized plants. Guler et al. [66] observed similar effects during the colonization of maize seedlings by Trichoderma atroviride. Most likely, the effect of endophytes on the content and composition of photosynthesizing pigments depends largely on the method of inoculation, the duration of colonization, the composition of the substrate for plant growth, and certain endophyte-plant systems.
The obtained data indicate the presence of oxidative stress in plants in their initial interaction with both species of fungi. MDA is widely used as a marker of LPO [67]. We found a statistically significant increase in the TBARS level in the roots under the action of both fungi, i.e., in the zone of direct contact of plants with conidia. Furthermore, in the potato leaves during colonization with M. robertsii, a significant increase in TBARS was detected, which agreed with the more pronounced effect of M. robertsii compared to B. bassiana.
We established a change in the activity of antioxidant enzymes in leaves under the influence of EIPF. In particular, inoculation with M. robertsii led to a significant increase in POX activity. Slight increasing trends were observed for SOD and POX activities after B. bassiana treatments, but differences were insignificant compared to control plants. These data are consistent with studies on the effects of other fungal endophytes on plants. An increase in the level of antioxidant enzymes in response to inoculation with Trichoderma harzianum has been shown in tomato seedlings [68] and Ochradenus baccatus [69]. Bagy et al. [70] registered a slight increase in SOD levels and a significant increase in ascorbate peroxidase activity after inoculation of potatoes with the endophytic fungus Epicoccum nigrum. Peroxidase is involved in the formation and lignification of cell walls (lignin and suberin formation) and in the protection of plant tissues from damage caused by microorganisms [71,72]. Therefore, it can be proposed that in its early stages, plants respond to endophyte colonization as an attack on pathogens, which leads to the activation of defense systems.
Proline plays an important role in plant stress resistance. It has been shown that proline accumulates in plants under unfavorable conditions [73]. Usually, proline accumulation is estimated to function as an osmoprotectant and a molecular chaperone in plants, specifically for salinity and drought [74,75]. Proline also has a role in scavenging ROS and shows singlet oxygen quenching ability [76]. To our knowledge, there is no information about the effect of EIPF on the level of free proline in colonized plants. However, there is much experimental evidence about proline accumulation in plants colonized by mycorrhizal fungi and obligate endophytes, particularly under osmotic stress conditions [77,78,79]. We found that proline accumulates actively in the stems of plants treated with M. robertsii. It is likely that proline accumulation in plants may also indicate a response to initial colonization by EIPF, but this aspect still remains to be studied in detail.
The decreased response of plants to colonization by B. bassiana compared to that by M. robertsii allows us to speculate that B. bassiana is more adapted to endophytism. The defense reactions of Solanaceae generally occur earlier and largely against microorganisms incompatible with them, preventing their successful development in plant tissue as a result [80]. The degree of colonization of different plant tissues with EIPF supports this assumption. In particular, M. robertsii mainly colonizes the roots [81,82], but B. bassiana has been isolated from almost all plant organs [83,84]. Moreover, Ahmad et al. [28] found that genes related to the SA pathway are mainly expressed in maize in response to M. robertsii colonization. The authors suggest that the plant may have perceived M. robertsii as a biotrophic pathogen. A study of Arabidopsis thaliana gene expression in response to colonization with B. bassiana strains showed changes in the expression of genes related to both JA and SA signaling pathways [14].
5. Conclusions
The obtained results support the hypothesis that in the early stages of communication between plants and fungi, EIPF may act as an elicitor leading to activation of enzymatic and nonenzymatic defense reactions in potato plants. Activation of these responses may be costly for plants and lead to growth retardation. We observed a slight decrease in the biomass and linear dimensions, as well as in leaf surface area and the content of photosynthetic pigments, in potato plants. Considering the high amount of data on the stimulation of plant growth under the influence of endophytes, it can be proposed that the slight retardation caused by the initial contact with EIPF does not exceed the normal reaction in plants and can be quickly compensated. The effect of EIPF on plants depends on the species and strain of the fungus. This fact needs to be studied in detail in the future, especially during the selection of the plant and fungal pairs to reach the greatest useful effect.
Author Contributions
Conceptualization, O.G.T. and V.Y.K.; methodology, M.V.E.; software, O.G.T.; validation, M.V.E., V.Y.K., and V.V.G.; formal analysis, I.S.K., L.V.K., and N.A.K.; investigation, I.S.K., L.V.K., and N.A.K.; resources, M.V.E. and V.V.G.; data curation, I.S.K. and L.V.K.; writing—original draft preparation, O.G.T. and N.A.K.; writing—review and editing, M.V.E., V.Y.K., and V.V.G.; visualization, O.G.T.; supervision, V.V.G.; project administration, V.V.G.; funding acquisition, V.V.G. All authors have read and agreed to the published version of the manuscript.
Funding
This research was funded by Russian Science Found (RSF), grant number 19-14-00138.
Informed Consent Statement
Informed consent was obtained from all subjects involved in the study.
Data Availability Statement
The authors will make the results available if requested.
Conflicts of Interest
The authors declare no conflict of interest.
Appendix A

Figure A1.
Growing plants in the laboratory: (a) Cultivation of potato plantlets on Murashige and Skoog agar medium; (b) Cultivation of potato seedlings in a liquid half-strength modified Murashige and Skoog agar medium (without sucrose and agar).

Figure A2.
Root colonization by entomopathogenic fungi: (a) M. robertsii (strain P-72); (b) B. bassiana (strain Sar-31). Light microscopy (with magnification 200×), scale bar: 50 μm. The areas of fungal penetration into the root tissues are shown by arrows.
References
- Bills, G.F.; Polishook, J.D. Microfungi from Carpinus caroliniana. Can. J. Bot. 1990, 69, 1477–1482. [Google Scholar] [CrossRef]
- Bing, L.A.; Lewis, L.C. Suppression of Ostrinia nubilalis (Hübner) (Lepidoptera: Pyralidae) by Endophytic Beauveria bassiana (Balsamo) Vuillemin. Environ. Entomol. 1991, 20, 1207–1211. [Google Scholar] [CrossRef]
- Bamisile, B.S.; Dash, C.K.; Akutse, K.S.; Keppanan, R.; Wang, L. Fungal Endophytes: Beyond Herbivore Management. Front. Microbiol. 2018, 9, 544. [Google Scholar] [CrossRef] [Green Version]
- Jaber, L.R.; Ownley, B.H. Can we use entomopathogenic fungi as endophytes for dual biological control of insect pests and plant pathogens? Biol. Control 2018, 116, 36–45. [Google Scholar] [CrossRef]
- Vega, F.E. The use of fungal entomopathogens as endophytes in biological control: A review. Mycologia 2018, 110, 4–30. [Google Scholar] [CrossRef]
- Branine, M.; Bazzicalupo, A.; Branco, S. Biology and applications of endophytic insect-pathogenic fungi. PLoS Pathog. 2019, 15, e1007831. [Google Scholar] [CrossRef] [Green Version]
- Mantzoukas, S.; Eliopoulos, P.A. Endophytic Entomopathogenic Fungi: A Valuable Biological Control Tool against Plant Pests. Appl. Sci. 2020, 10, 360. [Google Scholar] [CrossRef] [Green Version]
- Hu, S.; Bidochka, M.J. Root colonization by endophytic insect-pathogenic fungi. J. Appl. Microbiol. 2021, 130, 570–581. [Google Scholar] [CrossRef] [PubMed]
- Lacey, L.A.; Grzywacz, D.; Shapiro-Ilan, D.I.; Frutos, R.; Brownbridge, M.; Goettel, M.S. Insect pathogens as biological control agents: Back to the future. J. Invertebr. Pathol. 2015, 132, 1–41. [Google Scholar] [CrossRef] [PubMed] [Green Version]
- Jaronski, S.T.; Mascarin, G.M. Mass production of fungal Entomopathogens. In Microbial Control of Insect and Mite Pests: From Theory to Practice; Lacey, L.A., Ed.; Academic Press: Cambridge, MA, USA, 2016; pp. 141–155, Chapter 9. [Google Scholar] [CrossRef]
- Behie, S.W.; Zelisko, P.M.; Bidochka, M.J. Endophytic Insect-Parasitic Fungi Translocate Nitrogen Directly from Insects to Plants. Science 2012, 336, 1576–1577. [Google Scholar] [CrossRef] [PubMed] [Green Version]
- Behie, S.W.; Bidochka, M.J. Ubiquity of Insect-Derived Nitrogen Transfer to Plants by Endophytic Insect-Pathogenic Fungi: An Additional Branch of the Soil Nitrogen Cycle. Appl. Environ. Microbiol. 2014, 80, 1553–1560. [Google Scholar] [CrossRef] [PubMed] [Green Version]
- Gómez-Vidal, S.; Salinas, J.; Tena, M.; Lopez-Llorca, L.V. Proteomic analysis of date palm (Phoenix dactylifera L.) responses to endophytic colonization by entomopathogenic fungi. Electrophoresis 2009, 30, 2996–3005. [Google Scholar] [CrossRef] [PubMed]
- Raad, M.; Glare, T.R.; Brochero, H.L.; Müller, C.; Rostás, M. Transcriptional reprogramming of Arabidopsis thaliana defence pathways by the entomopathogen Beauveria bassiana correlates with resistance against a fungal pathogen but not against insects hormones, plant–microbe interaction, Plutella xylostella, Myzus persicae, Sclerotinia sclerotiorum. Front. Microbiol. 2019, 10, 615. [Google Scholar] [CrossRef] [PubMed] [Green Version]
- Liao, X.; Lovett, B.; Fang, W.; St Leger, R.J. Metarhizium robertsii produces indole-3-acetic acid, which promotes root growth in Arabidopsis and enhances virulence to insects. Microbiology 2017, 163, 980–991. [Google Scholar] [CrossRef]
- Flori, P.; Roberti, R. La concia dei bulbi di cipolla con antagonisti fungini per il contenimento di Fusarium oxysporum f. sp. cepae. La Difesa delle Piante 1993, 16, 5–12. [Google Scholar]
- Griffin, M.R.; Ownley, B.H.; Klingeman, W.E.; Pereira, R.M. Biocontrol of Rhizoctonia damping-off of cotton with endophytic Beauveria bassiana. Phytopathology 2005, 95, S36. [Google Scholar]
- Ownley, B.H.; Dee, M.M.; Gwinn, K. Effect of conidial seed treatment rate of entomopathogenic Beauveria bassiana 11-98 on endophytic colonization of tomato seedlings and control of Rhizoctonia disease. Phytopathology 2008, 98, S118. [Google Scholar]
- Ownley, B.H.; Griffin, M.R.; Klingeman, W.E.; Gwinn, K.D.; Moulton, J.K.; Pereira, R.M. Beauveria bassiana: Endophytic colonization and plant disease control. J. Invertebr. Pathol. 2008, 98, 267–270. [Google Scholar] [CrossRef]
- Barra-Bucarei, L.; Iglesias, A.F.; González, M.G.; Aguayo, G.S.; Carrasco-Fernández, J.; Castro, J.F.; Campos, J.O. Antifungal Activity of Beauveria bassiana Endophyte against Botrytis cinerea in Two Solanaceae Crops. Microorganisms 2020, 8, 65. [Google Scholar] [CrossRef] [PubMed] [Green Version]
- Gao, F.-K.; Dai, C.-C.; Liu, X.-Z. Mechanisms of fungal endophytes in plant protection against pathogens. Afr. J. Microbiol. Res. 2010, 4, 1346–1351. [Google Scholar]
- Sasan, R.K.; Bidochka, M.J. Antagonism of the endophytic insect pathogenic fungus Metarhizium robertsii against the bean plant pathogen Fusarium solani f. sp. phaseoli. Can. J. Plant Pathol. 2013, 35, 288–293. [Google Scholar] [CrossRef]
- Lozano-Tovar, M.D.; Garrido-Jurado, I.; Quesada-Moraga, E.; Raya-Ortega, M.C.; Trapero-Casas, A. Metarhizium brunneum and Beauveria bassiana release secondary metabolites with antagonistic activity against Verticillium dahliae and Phytophthora megasperma olive pathogens. Crop Prot. 2017, 100, 186–195. [Google Scholar] [CrossRef]
- Kang, B.R.; Han, J.H.; Kim, J.J.; Kim, Y.C. Dual Biocontrol Potential of the Entomopathogenic Fungus, Isaria javanica, for Both Aphids and Plant Fungal Pathogens. Mycobiology 2018, 46, 440–447. [Google Scholar] [CrossRef] [PubMed] [Green Version]
- Hirano, E.; Koike, M.; Aiuchi, D.; Tani, M. Pre-inoculation of cucumber roots with Verticillium lecanii (Lecanicillium muscarium) induces resistance to powdery mildew. Res. Bull. Obihiro Univ. 2008, 29, 82–94. [Google Scholar]
- Maksimov, I.V.; Sorokan, A.V.; Nafikova, A.R.; Benkovskaya, G.V. On principal ability and action mechanisms of joint use of Bacillus subtilis 26D and Beauveria bassiana Ufa-2 preparation for potato protection against Phytophthora infestans and Leptinotarsa decemlineata. Micologia i fitopatologia 2015, 49, 317–324. [Google Scholar]
- Prabhukarthikeyan, S.R.; Keerthana, U.; Archana, S.; Raguchander, T. Induced resistance in tomato plants to Helicoverpa armigera by mixed formulation of Bacillus subtilis and Beauveria bassiana. Res. J. Biotechnol. 2017, 12, 53–59. [Google Scholar]
- Ahmad, I.; Jiménez-Gasco, M.D.M.; Luthe, D.S.; Shakeel, S.N.; Barbercheck, M.E. Endophytic Metarhizium robertsii promotes maize growth, suppresses insect growth, and alters plant defense gene expression. Biol. Control 2020, 144, 104167. [Google Scholar] [CrossRef]
- Tomilova, O.G.; Shaldyaeva, E.M.; Kryukova, N.A.; Pilipova, Y.V.; Schmidt, N.S.; Danilov, V.P.; Kryukov, V.Y.; Glupov, V.V. Entomopathogenic fungi decrease Rhizoctonia disease in potato in field conditions. PeerJ 2020, 8, e9895. [Google Scholar] [CrossRef]
- Yi, H.-S.; Yang, J.W.; Ryu, C.-M. ISR meets SAR outside: Additive action of the endophyte Bacillus pumilus INR7 and the chemical inducer, benzothiadiazole, on induced resistance against bacterial spot in field-grown pepper. Front. Plant Sci. 2013, 4, 122. [Google Scholar] [CrossRef] [Green Version]
- Pieterse, C.M.; Zamioudis, C.; Berendsen, R.L.; Weller, D.M.; Van Wees, S.C.; Bakker, P.A. Induced Systemic Resistance by Beneficial Microbes. Annu. Rev. Phytopathol. 2014, 52, 347–375. [Google Scholar] [CrossRef] [Green Version]
- Fontana, D.C.; de Paula, S.; Torres, A.G.; de Souza, V.H.M.; Pascholati, S.F.; Schmidt, D.; Dourado, N.D. Endophytic Fungi: Biological Control and Induced Resistance to Phytopathogens and Abiotic Stresses. Pathogens 2021, 10, 570. [Google Scholar] [CrossRef]
- Mittler, R. Oxidative stress, antioxidants and stress tolerance. Trends Plant Sci. 2002, 7, 405–410. [Google Scholar] [CrossRef]
- Oliveira, M.; Varanda, C.; Felix, M. Induced resistance during the interaction pathogen x plant and the use of resistance inducers. Phytochem. Lett. 2016, 15, 152–158. [Google Scholar] [CrossRef] [Green Version]
- Noctor, G.; Reichheld, J.-P.; Foyer, C.H. ROS-related redox regulation and signaling in plants. Semin. Cell Dev. Biol. 2017, 80, 3–12. [Google Scholar] [CrossRef] [PubMed] [Green Version]
- Verbruggen, N.; Hermans, C. Proline accumulation in plants: A review. Amino Acids 2008, 35, 753–759. [Google Scholar] [CrossRef] [PubMed]
- Kavi-Kishor, P.B.; Sreenivasulu, N. Is proline accumulationper secorrelated with stress tolerance or is proline homeostasis a more critical issue? Plant Cell Environ. 2014, 37, 300–311. [Google Scholar] [CrossRef]
- Heil, M. The Ecological Concept of Costs of Induced Systemic Resistance (ISR). Eur. J. Plant Pathol. 2001, 107, 137–146. [Google Scholar] [CrossRef]
- Tyurin, M.; Kabilov, M.R.; Smirnova, N.; Tomilova, O.G.; Yaroslavtseva, O.; Alikina, T.; Glupov, V.V.; Kryukov, V.Y. Can Potato Plants Be Colonized with the Fungi Metarhizium and Beauveria under Their Natural Load in Agrosystems? Microorganisms 2021, 9, 1373. [Google Scholar] [CrossRef]
- Ríos-Moreno, A.; Garrido-Jurado, I.; Resquín-Romero, G.; Arroyo-Manzanares, N.; Arce, L.; Quesada-Moraga, E. Destruxin A production by Metarhizium brunneum strains during transient endophytic colonisation of Solanum tuberosum. Biocontrol Sci. Technol. 2016, 26, 1574–1585. [Google Scholar] [CrossRef]
- Krell, V.; Unger, S.; Jakobs-Schoenwandt, D.; Patel, A.V. Endophytic Metarhizium brunneum mitigates nutrient deficits in potato and improves plant productivity and vitality. Fungal Ecol. 2018, 34, 43–49. [Google Scholar] [CrossRef]
- Sheibani-Tezerji, R.; Rattei, T.; Sessitsch, A.; Trognitz, F.; Mitter, B. Transcriptome Profiling of the Endophyte Burkholderia phytofirmans PsJN Indicates Sensing of the Plant Environment and Drought Stress. mBio 2015, 6, e00621-15. [Google Scholar] [CrossRef] [Green Version]
- Turbat, A.; Rakk, D.; Vigneshwari, A.; Kocsubé, S.; Thu, H.; Szepesi, Á.; Bakacsy, L.; Škrbić, B.D.; Jigjiddorj, E.-A.; Vágvölgyi, C.; et al. Characterization of the Plant Growth-Promoting Activities of Endophytic Fungi Isolated from Sophora flavescens. Microorganisms 2020, 8, 683. [Google Scholar] [CrossRef]
- Kryukov, V.Y.; Yaroslavtseva, O.N.; Tyurin, M.V.; Akhanaev, Y.B.; Elisaphenko, E.; Wen, T.-C.; Tomilova, O.G.; Tokarev, Y.S.; Glupov, V.V. Ecological preferences of Metarhizium spp. from Russia and neighboring territories and their activity against Colorado potato beetle larvae. J. Invertebr. Pathol. 2017, 149, 1–7. [Google Scholar] [CrossRef]
- Murashige, T.; Skoog, F. A Revised Medium for Rapid Growth and Bio Assays with Tobacco Tissue Cultures. Physiol. Plant. 1962, 15, 473–497. [Google Scholar] [CrossRef]
- Posada, F.; Aime, M.C.; Peterson, S.W.; Rehner, S.A.; Vega, F.E. Inoculation of coffee plants with the fungal entomopathogen Beauveria bassiana (Ascomycota: Hypocreales). Mycol. Res. 2007, 111, 748–757. [Google Scholar] [CrossRef] [Green Version]
- McKinnon, A.C.; Saari, S.; Moran-Diez, M.E.; Meyling, N.V.; Raad, M.; Glare, T.R. Beauveria bassiana as an endophyte: A critical review on associated methodology and biocontrol potential. BioControl 2017, 62, 1–17. [Google Scholar] [CrossRef]
- Lichtenthaler, H.K. Chlorophylls and carotenoids: Pigments of photosynthetic biomembranes. Methods Enzymol. 1987, 148, 350–382. [Google Scholar] [CrossRef]
- Heath, R.L.; Packer, L. Photoperoxidation in isolated chloroplasts: I. Kinetics and stoichiometry of fatty acid peroxidation. Arch. Biochem. Biophys. 1968, 125, 189–198. [Google Scholar] [CrossRef]
- Beauchamp, C.; Fridovich, I. Superoxide dismutase: Improved assays and an assay applicable to acrylamide gels. Anal. Biochem. 1971, 44, 276–287. [Google Scholar] [CrossRef]
- Shevyakova, N.I.; Stetsenko, L.A.; Meshcheryakov, A.B.; Kuznetsov, V.V. The Activity of the Peroxidase System in the Course of Stress-Induced CAM Development. Russ. J. Plant Physiol. 2002, 49, 598–604. [Google Scholar] [CrossRef]
- Esen, A. A simple method for quantitative, semiquantitative, and qualitive assay of protein. Anal. Biochem. 1978, 89, 264–327. [Google Scholar] [CrossRef]
- Bates, L.S.; Waldren, R.P.; Teare, I.D. Rapid determination of free proline for water-stress studies. Plant Soil 1973, 39, 205–207. [Google Scholar] [CrossRef]
- Hammer, Ø.; Harper, D.A.T.; Ryan, P.D. PAST: Paleontological statistics software package for education and data analysis. Palaeontol. Electron. 2001, 4, 1–9. [Google Scholar]
- Jaber, L.R.; Araj, S.-E. Interactions among endophytic fungal entomopathogens (Ascomycota: Hypocreales), the green peach aphid Myzus persicae Sulzer (Homoptera: Aphididae), and the aphid endoparasitoid Aphidius colemani Viereck (Hymenoptera: Braconidae). Biol. Control 2018, 116, 53–61. [Google Scholar] [CrossRef]
- García, J.E.; Posadas, J.B.; Perticari, A.; Lecuona, R.E. Metarhizium anisopliae (Metschnikoff) Sorokin promotes growth and has endophytic activity in tomato plants. Advan. Biol. Res. 2011, 5, 22–27. [Google Scholar]
- Barra-Bucarei, L.; González, M.G.; Iglesias, A.F.; Aguayo, G.S.; Peñalosa, M.G.; Vera, P.V. Beauveria bassiana Multifunction as an Endophyte: Growth Promotion and Biologic Control of Trialeurodes vaporariorum, (Westwood) (Hemiptera: Aleyrodidae) in Tomato. Insects 2020, 11, 591. [Google Scholar] [CrossRef] [PubMed]
- Kryukov, V.Y.; Kabilov, M.R.; Smirnova, N.; Tomilova, O.G.; Tyurin, M.V.; Akhanaev, Y.B.; Polenogova, O.V.; Danilov, V.P.; Zhangissina, S.K.; Alikina, T.; et al. Bacterial decomposition of insects post-Metarhizium infection: Possible influence on plant growth. Fungal Biol. 2019, 123, 927–935. [Google Scholar] [CrossRef] [PubMed]
- Krell, V.; Unger, S.; Jakobs-Schoenwandt, D.; Patel, A.V. Importance of phosphorus supply through endophytic Metarhizium brunneum for root:shoot allocation and root architecture in potato plants. Plant Soil 2018, 430, 87–97. [Google Scholar] [CrossRef]
- Verma, S.K.; Sahu, P.K.; Kumar, K.; Pal, G.; Gond, S.K.; Kharwar, R.N.; White, J.F. Endophyte roles in nutrient acquisition, root system architecture development and oxidative stress tolerance. J. Appl. Microbiol. 2021. [Google Scholar] [CrossRef]
- Raya-Díaz, S.; Sánchez-Rodríguez, A.R.; Segura-Fernández, J.M.; Campillo, M.D.C.D.; Quesada-Moraga, E. Entomopathogenic fungi-based mechanisms for improved Fe nutrition in sorghum plants grown on calcareous substrates. PLoS ONE 2017, 12, e0185903. [Google Scholar] [CrossRef] [PubMed] [Green Version]
- Sánchez-Rodríguez, A.R.; del Campillo, M.C.; Quesada-Moraga, E. Beauveria bassiana: An entomopathogenic fungus alleviates Fe chlorosis symptoms in plants grown on calcareous substrates. Sci. Hortic. 2015, 197, 193–202. [Google Scholar] [CrossRef]
- Sánchez-Rodríguez, A.R.; Barrón, V.; del Campillo, M.C.; Quesada-Moraga, E. The entomopathogenic fungus Metarhizium brunneum: A tool for alleviating Fe chlorosis. Plant Soil 2016, 406, 295–310. [Google Scholar] [CrossRef]
- Kumar, C.M.S.; Jacob, T.K.; Devasahayam, S.; Thomas, S.; Geethu, C. Multifarious plant growth promotion by an entomopathogenic fungus Lecanicillium psalliotae. Microbiol. Res. 2017, 207, 153–160. [Google Scholar] [CrossRef]
- Racić, G.; Vukelić, I.; Prokić, L.; Ćurčić, N.; Zorić, M.; Jovanović, L.; Panković, D. The influence of Trichoderma brevicompactum treatment and drought on physiological parameters, abscisic acid content and signalling pathway marker gene expression in leaves and roots of tomato. Ann. Appl. Biol. 2018, 173, 213–221. [Google Scholar] [CrossRef]
- Guler, N.S.; Pehlivan, N.; Karaoglu, S.A.; Guzel, S.; Bozdeveci, A. Trichoderma atroviride ID20G inoculation ameliorates drought stress-induced damages by improving antioxidant defence in maize seedlings. Acta Physiol. Plant. 2016, 38, 132. [Google Scholar] [CrossRef]
- Mosblech, A.; Feussner, I.; Heilmann, I. Oxylipins: Structurally diverse metabolites from fatty acid oxidation. Plant Physiol. Biochem. 2009, 47, 511–517. [Google Scholar] [CrossRef] [PubMed]
- Mastouri, F.; Björkman, T.; Harman, G.E. Trichoderma harzianum Enhances Antioxidant Defense of Tomato Seedlings and Resistance to Water Deficit. Mol. Plant-Microbe Interact. 2012, 25, 1264–1271. [Google Scholar] [CrossRef] [Green Version]
- Hashem, A.; Abd Allah, E.F.; Alqarawi, A.A.; Al Huqail, A.A.; Egamberdieva, D. Alleviation of abiotic salt stress in Ochradenus baccatus (Del.) by Trichoderma hamatum (Bonord.) Bainier. J. Plant Interact. 2014, 9, 857–868. [Google Scholar] [CrossRef]
- Bagy, H.M.M.K.; Hassan, E.A.; Nafady, N.A.; Dawood, M.F.A. Efficacy of arbuscular mycorrhizal fungi and endophytic strain Epicoccum nigrum ASU11 as biocontrol agents against blackleg disease of potato caused by bacterial strain Pectobacterium carotovora subsp. atrosepticum PHY. Biol. Control 2019, 134, 103–113. [Google Scholar] [CrossRef]
- Liu, Q.; Luo, L.; Zheng, L. Lignins: Biosynthesis and biological functions in plants. Int. J. Mol. Sci. 2018, 19, 335. [Google Scholar] [CrossRef] [PubMed] [Green Version]
- Almagro, L.; Gómez Ros, L.V.; Belchi-Navarro, S.; Bru, R.; Ros Barceló, A.; Pedreño, M.A. Class III peroxidases in plant defence reactions. J. Exp. Bot. 2008, 60, 377–390. [Google Scholar] [CrossRef] [PubMed] [Green Version]
- Ben Rejeb, K.; Abdelly, C.; Savouré, A. Proline, a multifunctional amino-acid involved in plant adaptation to environmental constraints. Biol. Aujourdhui 2012, 206, 291–299. [Google Scholar] [CrossRef]
- Chun, S.C.; Paramasivan, M.; Chandrasekaran, M. Proline Accumulation Influenced by Osmotic Stress in Arbuscular Mycorrhizal Symbiotic Plants. Front. Microbiol. 2018, 9, 2525. [Google Scholar] [CrossRef] [Green Version]
- Gupta, S.; Schillaci, M.; Walker, R.; Smith, P.M.C.; Watt, M.; Roessner, U. Alleviation of salinity stress in plants by endophytic plant-fungal symbiosis: Current knowledge, perspectives and future directions. Plant Soil 2021, 461, 219–244. [Google Scholar] [CrossRef]
- Kaur, G.; Asthir, B. Proline: A key player in plant abiotic stress tolerance. Biol. Plant. 2015, 59, 609–619. [Google Scholar] [CrossRef]
- Porcel, R.; Ruiz-Lozano, J.M. Arbuscular mycorrhizal influence on leaf water potential, solute accumulation, and oxidative stress in soybean plants subjected to drought stress. J. Exp. Bot. 2004, 55, 1743–1750. [Google Scholar] [CrossRef] [Green Version]
- Evelin, H.; Kapoor, R.; Giri, B. Arbuscular mycorrhizal fungi in alleviation of salt stress: A review. Ann. Bot. 2009, 104, 1263–1280. [Google Scholar] [CrossRef] [PubMed] [Green Version]
- Chitarra, W.; Pagliarani, C.; Maserti, B.; Lumini, E.; Siciliano, I.; Cascone, P.; Schubert, A.; Gambino, G.; Balestrini, R.; Guerrieri, E. Insights On the Impact of Arbuscular Mycorrhizal Symbiosis On Tomato Tolerance to Water Stress. Plant Physiol. 2016, 171, 1009–1023. [Google Scholar] [CrossRef] [Green Version]
- Desender, S.; Andrivon, D.; Val, F. Activation of defence reactions in Solanaceae: Where is the specificity? Cell. Microbiol. 2007, 9, 21–30. [Google Scholar] [CrossRef] [PubMed]
- St Leger, R.J. Studies on adaptations of Metarhizium anisopliae to life in the soil. J. Invertebr. Pathol. 2008, 98, 271–276. [Google Scholar] [CrossRef]
- Barelli, L.; Moreira, C.C.; Bidochka, M.J. Initial stages of endophytic colonization by Metarhizium involves rhizoplane colonization. Microbiology 2018, 164, 1531–1540. [Google Scholar] [CrossRef] [PubMed]
- Vega, F.E.; Posada, F.; Aime, M.C.; Pava-Ripoll, M.; Infante, F.S.; Rehner, A. Entomopathogenic fungal endophytes. Biol. Control 2008, 46, 72–82. [Google Scholar] [CrossRef] [Green Version]
- Behie, S.W.; Jones., S.J.; Bidochka, M.J. Plant tissue localization of the endophytic insect pathogenic fungi Metarhizium and Beauveria. Fungal Ecol. 2015, 13, 112–119. [Google Scholar] [CrossRef]
Publisher’s Note: MDPI stays neutral with regard to jurisdictional claims in published maps and institutional affiliations. |
© 2021 by the authors. Licensee MDPI, Basel, Switzerland. This article is an open access article distributed under the terms and conditions of the Creative Commons Attribution (CC BY) license (https://creativecommons.org/licenses/by/4.0/).